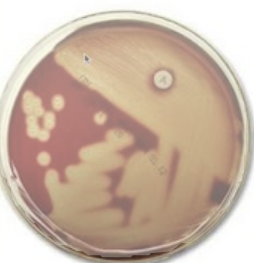
<p>Beta</p>
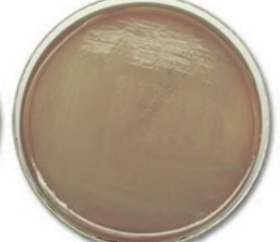
<p>Alpha </p>
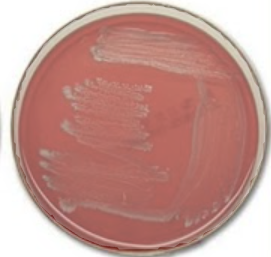
<p>Gamma </p>
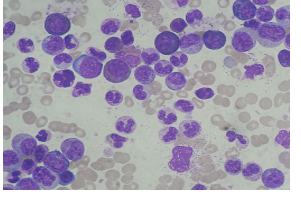
<p>Leukemia </p>
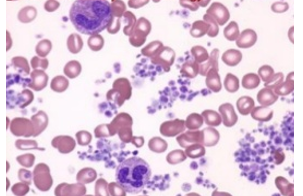
<p>Thrombocytosis </p>
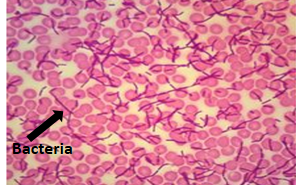
<p>Bacteremia/septicemia </p>

Practical 2
1/68
There's no tags or description
Looks like no tags are added yet.
Name | Mastery | Learn | Test | Matching | Spaced | Call with Kai |
|---|
No analytics yet
Send a link to your students to track their progress
69 Terms
What does the catalase test for?
The presence of catalase
Positive catalase result
Bubbles
Negative catalase result
No bubbles

Endospores
What does a blood agar show?
Whether bacteria produce hemolysin which breaks down RBC.
Beta
Complete RBC breakdown
Alpha
Partial RBC breakdown
Gamma
No RBC breakdown
What does MSA show?
Fermentation of mannitol.
What does yellow represent on MSA
Ferments mannitol
What does pink/colorless represent on MSA
Does not ferment mannitol
What does an EMB plate show?
Lactose fermentation
Green on EMB plate
Ferments lactose a lot
Purple on EMB plate
Ferments lactose a little
No shine on EMB plate
Does not ferment lactose
What does the SIM test show?
H2S production, indole production and motility

Contains nonmotile, and indole negative bacterium

Contains motile and indole positive bacterium

Contains motile, indole negative, and H2S producing bacterium
Indole positive result
Reagent turns red
What does methyl red detect?
The presence of a large concentration of acid end products
Methyl red positive reaction
Red


Methyl red negative reaction
Yellow
What does the VP test for?
Capability of organisms to produce nonacidic or neutral end products like acetoin.

Positive VP result
Red and white

Negative VP result
Green and yellow
What does the citrate utilization test for?
If an organism can use citrate as its only source of carbon

Positive citrate utilization result
Blue

Negative citrate utilization result
Green
LB (-pGLO)
Ampicillin sensitive E. coli will grow
LB + amp (-pGLO)
Ampicillin sensitive E. coli will not grow because it is sensitive to ampicillin
LB + amp (+pGLO)
Ampicillin sensitive E. coli will grow because pGLO is present
LB + amp + ara (+pGLO)
Ampicillin sensitive E. coli will glow because arabinose is present.
P (plain)
Strain 1 and strain 2 grow on it, and they mate
S (LB and streptomycin)
Strain 1 grows but not strain 2
A (LB and ampicillin)
Strain 1 does not grow but strain 2 does
N (LB and Nalidixic acid)
Strain 1 does not grow but strain 2 does
S and A (streptomycin and ampicillin)
Neither strain one or two grow, but they mate
Use of anaerobic jar, what goes in and why?
Organisms that grow in the throat (throat cultures), they add a GasPak pouch to absorb oxygen.
High susceptibility to dental caries
Yellow, fermentation of the glucose to lactic acid by bacteria in the saliva.
Low susceptibility dental caries
Green, less fermentation of the glucose to lactic acid by bacteria in the saliva.

Obligate aerobe

Obligate anaerobe

Facultative anaerobe

Microaerophile

Aerotolerant anaerobe

Neutrophil

Eosinophil

Basophil

Lymphocyte

Monocyte
Sickle cell anemia
Bent shape RBCs

Leukemia
Increased number of WBCs
Thrombocytosis
Increase number of platelets
Bacteremia/septicemia
Bacteria in blood
Thermal death time
The shortest length of time required to kill all test microbes at a specified temperature. First period where there is NOT growth.
UV sensitivity
The bacterium that is more sensitive will stop growth QUICKER
No ring present
Resistant
Ring present
Bacteria are susceptible to the antibiotic if within susceptibility spectrum.
Wet mount shows
Morphology and arrangement
Coagulase test
Detects the clumping factor (bound coagulase) present in the bacterial cell
Positive coagulase test
Agglutination occurs
Negative coagulase test
No agglutination occurs
What does DNAse test for?
Enzyme hydrolyzing DNA
Negative DNAse test
Clearing
Positive DNAse test
Opaque
CAMP test
Named after Chrisite Atkins Munch Peterson
Positive CAMP test
Arrowhead of hemolysis is visible, group B
Negative CAMP test
Arrowhead of hemolysis is not visible, group C/G/D